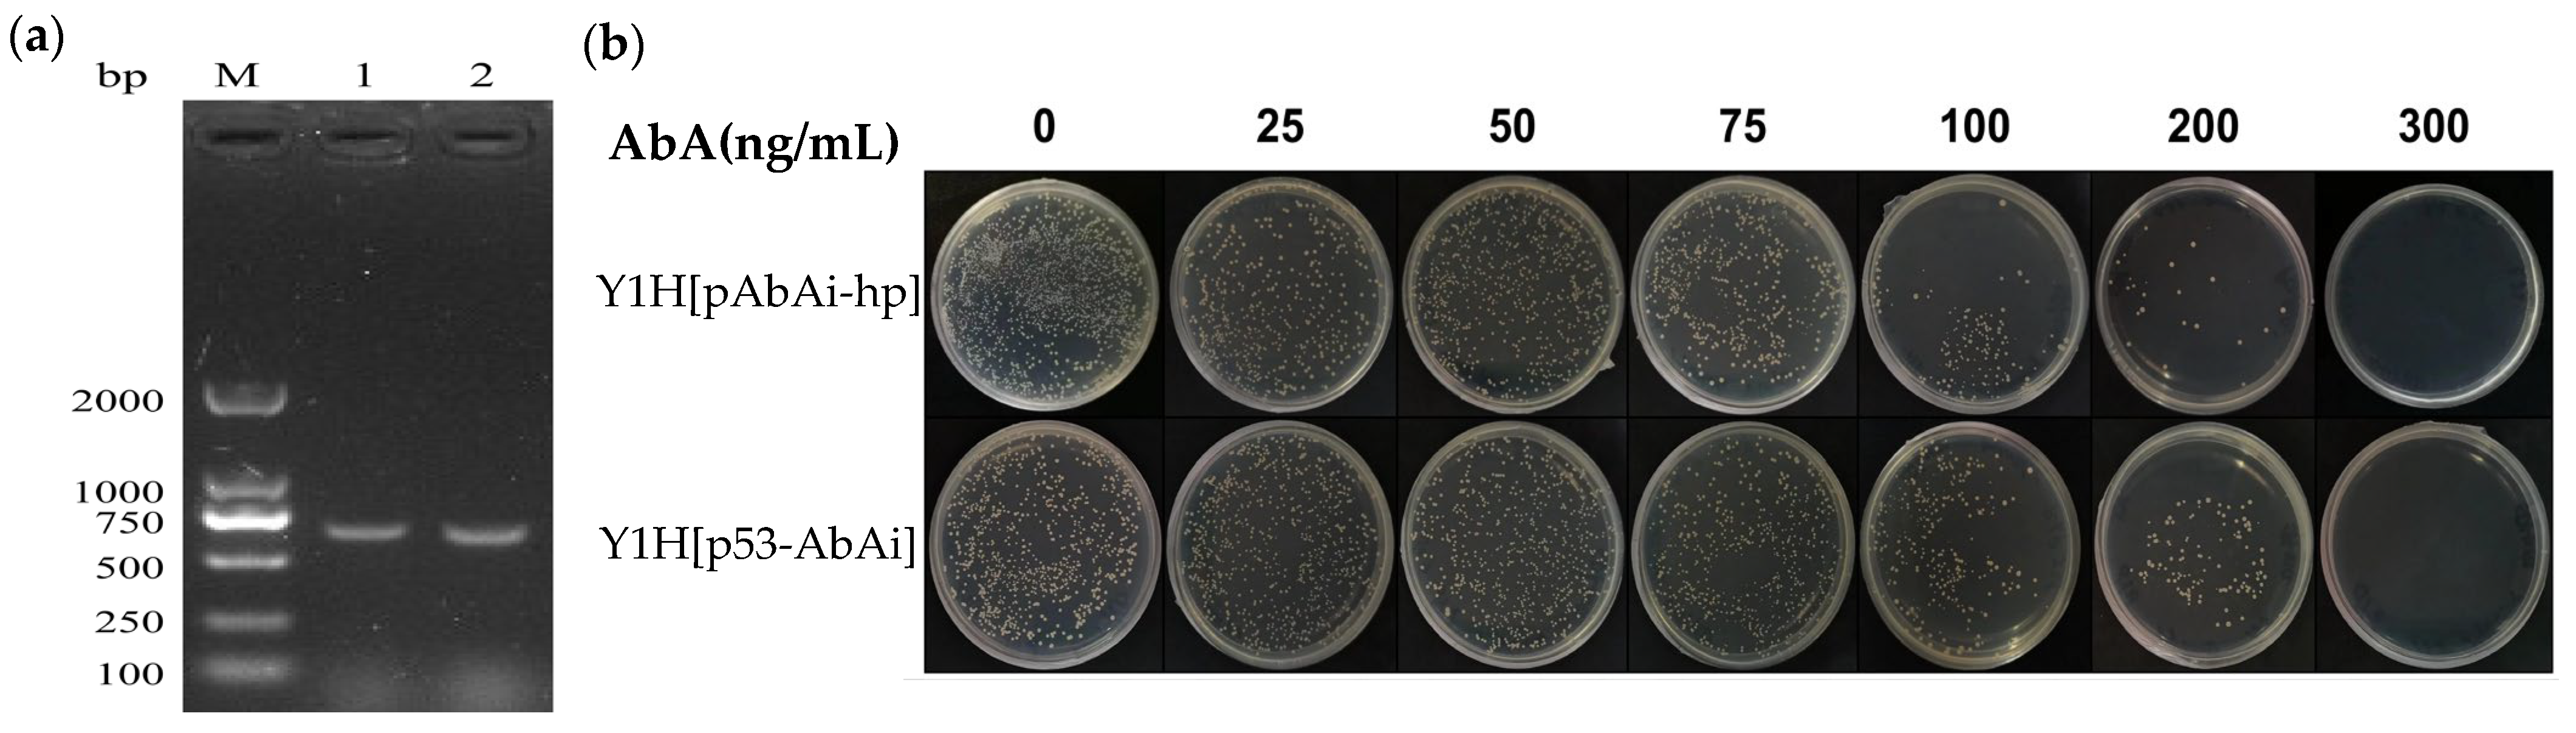
Jof 09 00822 g003

Construction of Yeast One-Hybrid Library of Alternaria oxytropis and Screening of Transcription Factors Regulating swnK Gene Expression
Abstract
1. Introduction
2. Materials and Methods
2.1. Fungal Culture
2.2. Prediction and Cloning of the 5′ Non-Coding Region of the swnK Gene
2.3. Analysis of Transcriptional Activity in the 5′ Upstream Regulatory Region of swnK Gene
2.4. RNA Extraction and Yeast One-Hybrid (Y1H) Library Construction
2.5. Construction of Bait Strain and Self-Activation Identification
2.6. Screening for Candidate Transcriptional Regulatory Molecules of swnK Gene
2.7. Confirmation of Positive Interaction
3. Results
3.1. Identification of Highly Transcriptively Active Regions in the 5′ Non-Coding Region of the swnK Gene
3.2. Construction of Y1H Library of A. Oxytropis UA003
3.3. Construction of Bait Strain and Self-Activation Identification Results
3.4. Screen Potential Transcriptional Regulators in the 5′ Highly Transcriptional Active Region of the swnK Gene Using Y1H
3.5. Verification of the Interaction between 5’ Upstream High Transcriptional Activity Region of the swnK Gene and Candidate Transcriptional Regulatory Molecules
3.6. Bioinformatics Analysis of the Selected C2H2 Transcription Factors
4. Discussion
5. Conclusions
Author Contributions
Funding
Institutional Review Board Statement
Informed Consent Statement
Data Availability Statement
Conflicts of Interest
References
- Welch, K.D.; Lee, S.T.; Cook, D.; Gardner, D.R.; Pfister, J.A. Chemical Analysis of Plants that Poison Livestock: Successes, Challenges, and Opportunities. J. Agr. Food Chem. 2018, 66, 3308–3314. [Google Scholar] [CrossRef]
- Guo, R.; Guo, Y.Z.; Wang, S.; Yang, C.; Su, Y.X.; Wu, C.C.; Lu, H.; Zhao, B.Y. Research Progress on Poisonous Plants of Natural Grassland and Poisonous Diseases of Grazing Livestock in China. J. Anim. Husb. Vet. Med. 2021, 52, 1171–1185. [Google Scholar]
- Daniel Cook, M.H.R.K.; Stegelmeier, A.B.L. Locoweed Poisoning in Livestock. Soc. Range Manag. 2009, 31, 16–20. [Google Scholar]
- Cholich, L.A.; Martinez, A.; Micheloud, J.F.; Pistán, M.E.; García, E.N.; Robles, C.A.; Ortega, H.H.; Gimeno, E.J. Alpha-mannosidosis caused by toxic plants in ruminants of Argentina. An. Acad. Bras. Ciências 2021, 93, e20191496. [Google Scholar] [CrossRef] [PubMed]
- Martinez, A.; Lauroua, C.; Borrelli, L.B.; Gardner, D.R.; Robles, C.A. Spontaneous outbreak of Astragalus pehuenches (Fabaceae) poisoning in cattle in Argentina. Toxicon 2019, 157, 84–86. [Google Scholar] [CrossRef] [PubMed]
- Yu, Y.; Zhao, Q.; Wang, J.; Wang, J.; Wang, Y.; Song, Y.; Geng, G.; Li, Q. Swainsonine-producing fungal endophytes from major locoweed species in China. Toxicon 2010, 56, 330–338. [Google Scholar] [CrossRef]
- Cook, D.; Gardner, D.R.; Martinez, A.; Robles, C.A.; Pfister, J.A. Screening for swainsonine among South American Astragalus species. Toxicon 2017, 139, 54–57. [Google Scholar] [CrossRef]
- Cook, D.; Gardner, D.R.; Pfister, J.A. Swainsonine-Containing Plants and Their Relationship to Endophytic Fungi. J. Agr. Food Chem. 2014, 62, 7326–7334. [Google Scholar] [CrossRef]
- Guan, H.; Liu, X.; Mur, L.A.J.; Fu, Y.; Wei, Y.; Wang, J.; He, W. Rethinking of the Roles of Endophyte Symbiosis and Mycotoxin in Oxytropis Plants. J. Fungi 2021, 7, 400. [Google Scholar] [CrossRef]
- Zhang, L.; Wu, R.; Mur, L.A.J.; Guo, C.; Zhao, X.; Meng, H.; Yan, D.; Zhang, X.; Guan, H.; Han, G.; et al. Assembly of high-quality genomes of the locoweed Oxytropis ochrocephala and its endophyte Alternaria oxytropis provides new evidence for their symbiotic relationship and swainsonine biosynthesis. Mol. Ecol. Resour. 2022, 23, 253–272. [Google Scholar] [CrossRef]
- Martinez, A.; Robles, C.A.; Roper, J.M.; Gardner, D.R.; Neyaz, M.S.; Joelson, N.Z.; Cook, D. Detection of swainsonine-producing endophytes in Patagonian Astragalus species. Toxicon 2019, 171, 1–6. [Google Scholar] [CrossRef] [PubMed]
- Alhawatema, M.S.; Sanogo, S.; Baucom, D.L.; Creamer, R. A Search for the Phylogenetic Relationship of the Ascomycete Rhizoctonia leguminicola Using Genetic Analysis. Mycopathologia 2015, 179, 381–389. [Google Scholar] [CrossRef]
- Cook, D.; Beaulieu, W.T.; Mott, I.W.; Riet-Correa, F.; Gardner, D.R.; Grum, D.; Pfister, J.A.; Clay, K.; Marcolongo-Pereira, C. Production of the Alkaloid Swainsonine by a Fungal Endosymbiont of the Ascomycete Order Chaetothyriales in the Host Ipomoea carnea. J. Agr. Food Chem. 2013, 61, 3797–3803. [Google Scholar] [CrossRef]
- Cook, D.; Donzelli, B.; Creamer, R.; Baucom, D.L.; Gardner, D.R.; Pan, J.; Moore, N.; Krasnoff, S.B.; Jaromczyk, J.W.; Schardl, C.L. Swainsonine Biosynthesis Genes in Diverse Symbiotic and Pathogenic Fungi. G3 Genes Genom. Genet. 2017, 7, 1791–1797. [Google Scholar] [CrossRef]
- Luo, F.; Hong, S.; Chen, B.; Yin, Y.; Tang, G.; Hu, F.; Zhang, H.; Wang, C. Unveiling of Swainsonine Biosynthesis via a Multibranched Pathway in Fungi. ACS Chem. Biol. 2020, 15, 2476–2484. [Google Scholar] [CrossRef] [PubMed]
- Baucom, D.L.; Romero, M.; Belfon, R.; Creamer, R. Two new species of Undifilum, fungal endophytes of Astragalus (locoweeds) in the United States. Botany 2012, 90, 866–875. [Google Scholar] [CrossRef]
- Cook, D.; Grum, D.S.; Gardner, D.R.; Welch, K.D.; Pfister, J.A. Influence of endophyte genotype on swainsonine concentrations in Oxytropis sericea. Toxicon 2013, 61, 105–111. [Google Scholar] [CrossRef] [PubMed]
- Guo, C.; Zhang, L.; Zhao, Q.; Beckmann, M.; Phillips, H.; Meng, H.; Mo, C.; Mur, L.A.J.; He, W. Host-Species Variation and Environment Influence Endophyte Symbiosis and Mycotoxin Levels in Chinese Oxytropis Species. Toxins 2022, 14, 181. [Google Scholar] [CrossRef]
- Neyaz, M.; Das, S.; Cook, D.; Creamer, R. Phylogenetic Comparison of Swainsonine Biosynthetic Gene Clusters among Fungi. J. Fungi 2022, 8, 359. [Google Scholar] [CrossRef]
- Liu, J.; Li, Y.; Creamer, R. A Re-examination of the Taxonomic Status of Embellisia astragali. Curr. Microbiol. 2016, 72, 404–409. [Google Scholar] [CrossRef]
- Pryor, B.M.; Creamer, R.; Shoemaker, R.A.; McLain-Romero, J.; Hambleton, S. Undifilum, a new genus for endophytic Embellisia oxytropis and parasitic Helminthosporium bornmuelleri on legumes. Botany 2009, 87, 178–194. [Google Scholar] [CrossRef]
- Reece-Hoyes, J.S.; Marian, W.A. Yeast one-hybrid assays: A historical and technical perspective. Methods 2012, 57, 441–447. [Google Scholar] [CrossRef] [PubMed]
- Fuxman, B.J.; Reece-Hoyes, J.S.; Walhout, A.J. Gene-Centered Yeast One-Hybrid Assays. Cold Spring Harb. Protoc. 2016, 2016, pdb.top077669. [Google Scholar] [CrossRef] [PubMed]
- Cao, Y.; Bi, M.; Yang, P.; Song, M.; He, G.; Wang, J.; Yang, Y.; Xu, L.; Ming, J. Construction of yeast one-hybrid library and screening of transcription factors regulating LhMYBSPLATTER expression in Asiatic hybrid lilies (Lilium spp.). BMC Plant Biol. 2021, 21, 563. [Google Scholar] [CrossRef] [PubMed]
- Bai, X.N.; Yu, Y.T.; Zhao, Q.M.; He, S.H.; Li, J.R. Isolation and identification of swainsonine-producing endophytic fungi from Astragalus variabilis. Anim. Husb. Vet. 2017, 49, 95–102. [Google Scholar]
- Lescot, M.; Dehais, P.; Thijs, G.; Marchal, K.; Moreau, Y.; Van de Peer, Y.; Rouze, P.; Rombauts, S. PlantCARE, a database of plant cis-acting regulatory elements and a portal to tools for in silico analysis of promoter sequences. Nucleic Acids Res. 2002, 30, 325–327. [Google Scholar] [CrossRef]
- Reese, M.G. Application of a time-delay neural network to promoter annotation in the Drosophila melanogaster genome. Comput. Chem. 2001, 26, 51–56. [Google Scholar] [CrossRef]
- Li, L.C.; Dahiya, R. MethPrimer: Designing primers for methylation PCRs. Bioinformatics 2002, 18, 1427–1431. [Google Scholar] [CrossRef]
- Lin, R.; He, L.; He, J.; Qin, P.; Wang, Y.; Deng, Q.; Yang, X.; Li, S.; Wang, S.; Wang, W.; et al. Comprehensive analysis of microRNA-Seq and target mRNAs of rice sheath blight pathogen provides new insights into pathogenic regulatory mechanisms. DNA Res. 2016, 23, 415–425. [Google Scholar] [CrossRef]
- Reece-Hoyes, J.S.; Walhout, A.J. Gene-centered yeast one-hybrid assays. Methods Mol. Biol. 2012, 812, 189–208. [Google Scholar] [CrossRef]
- Huang, E.; Zhang, Y.; Sun, L.; Zhu, Y.; Tang, S.; Mo, C.; Zhao, B.; Lu, H. swnk plays an important role in the biosynthesis of swainsonine in Metarhizium anisopliae. Biotechnol. Lett. 2023, 44, 509–519. [Google Scholar] [CrossRef] [PubMed]
- Yu, Y.T.; Mao, Y.N.; Zhao, Q.M.; Li, J.R.; Bai, X.N.; Xue, J.Q.; Zhang, H.D. Expression patterns analysis of related genes in SWN gene cluste of Alternaria oxytropis mutated by ethyl methylate. J. Anim. Sci. Vet. Med. 2022, 53, 1241–1251. [Google Scholar]
- Bin, A.G.; Buist, M.; Rastegar, M. MeCP2 and transcriptional control of eukaryotic gene expression. Eur. J. Cell Biol. 2022, 101, 151237. [Google Scholar] [CrossRef]
- Zabidi, M.A.; Stark, A. Regulatory Enhancer-Core-Promoter Communication via Transcription Factors and Cofactors. Trends Genet. 2016, 32, 801–814. [Google Scholar] [CrossRef] [PubMed]
- Ptashne, M. Regulation of transcription: From lambda to eukaryotes. Trends Biochem. Sci. 2005, 30, 275–279. [Google Scholar] [CrossRef]
- Pimprikar, P.; Gutjahr, C. Transcriptional Regulation of Arbuscular Mycorrhiza Development. Plant Cell Physiol. 2018, 59, 673–690. [Google Scholar] [CrossRef]
- Nguyen, D.X.; Sakaguchi, T.; Nakazawa, T.; Sakamoto, M.; Honda, Y. A 14-bp stretch plays a critical role in regulating gene expression from β1-tubulin promoters of basidiomycetes. Curr. Genet. 2020, 66, 217–228. [Google Scholar] [CrossRef]
- Kwon, B.R.; Kim, M.J.; Park, J.A.; Chung, H.J.; Kim, J.M.; Park, S.M.; Yun, S.H.; Yang, M.S.; Kim, D.H. Assessment of the core cryparin promoter from Cryphonectria parasitica for heterologous expression in filamentous fungi. Appl. Microbiol. Biot. 2009, 83, 339–348. [Google Scholar] [CrossRef]
- Fan, S.; Li, X.; Lin, S.; Li, Y.; Ma, H.; Zhang, Z.; Qin, Z. Screening and Identification of Transcription Factors Potentially Regulating Foxl2 Expression in Chlamys farreri Ovary. Biology 2022, 11, 113. [Google Scholar] [CrossRef]
- Vo, N.L.; Kassavetis, G.A.; Kadonaga, J.T. The RNA Polymerase II Core Promoter in Drosophila. Genetics 2019, 212, 13–24. [Google Scholar] [CrossRef]
- Cramer, P. Organization and regulation of gene transcription. Nature 2019, 573, 45–54. [Google Scholar] [CrossRef]
- Jones, D.; John, E.; Rybak, K.; Phan, H.; Singh, K.B.; Lin, S.Y.; Solomon, P.S.; Oliver, R.P.; Tan, K.C. A specific fungal transcription factor controls effector gene expression and orchestrates the establishment of the necrotrophic pathogen lifestyle on wheat. Sci. Rep. 2019, 9, 15884. [Google Scholar] [CrossRef] [PubMed]
- Teichmann, B.; Liu, L.; Schink, K.O.; Bolker, M. Activation of the ustilagic acid biosynthesis gene cluster in Ustilago maydis by the C2H2 zinc finger transcription factor Rua1. Appl. Environ. Microb. 2010, 76, 2633–2640. [Google Scholar] [CrossRef] [PubMed]
- Song, D.; Cao, Y.; Xia, Y. Transcription Factor MaMsn2 Regulates Conidiation Pattern Shift under the Control of MaH1 through Homeobox Domain in Metarhizium acridum. J. Fungi 2021, 7, 840. [Google Scholar] [CrossRef] [PubMed]
- Liu, T.; Qin, J.; Cao, Y.; Subbarao, K.V.; Chen, J.; Mandal, M.K.; Xu, X.; Shang, W.; Hu, X. Transcription Factor VdCf2 Regulates Growth, Pathogenicity, and the Expression of a Putative Secondary Metabolism Gene Cluster in Verticillium dahliae. Appl. Environ. Microb. 2022, 88, e138522. [Google Scholar] [CrossRef]
- Fasoyin, O.E.; Wang, B.; Qiu, M.; Han, X.; Chung, K.R.; Wang, S. Carbon catabolite repression gene creA regulates morphology, aflatoxin biosynthesis and virulence in Aspergillus flavus. Fungal Genet. Biol. 2018, 115, 41–51. [Google Scholar] [CrossRef]
- Ren, S.; Yang, M.; Li, Y.; Zhang, F.; Chen, Z.; Zhang, J.; Yang, G.; Yue, Y.; Li, S.; Ge, F.; et al. Global Phosphoproteomic Analysis Reveals the Involvement of Phosphorylation in Aflatoxins Biosynthesis in the Pathogenic Fungus Aspergillus flavus. Sci. Rep. 2016, 6, 34078. [Google Scholar] [CrossRef]
- Preisinger, C.; von Kriegsheim, A.; Matallanas, D.; Kolch, W. Proteomics and phosphoproteomics for the mapping of cellular signalling networks. Proteomics 2008, 8, 4402–4415. [Google Scholar] [CrossRef]
- Marino-Ramirez, L.; Hsu, B.; Baxevanis, A.D.; Landsman, D. The Histone Database: A comprehensive resource for histones and histone fold-containing proteins. Proteins 2006, 62, 838–842. [Google Scholar] [CrossRef]
- Cooper, J.L.; Henikoff, S. Adaptive evolution of the histone fold domain in centromeric histones. Mol. Biol. Evol. 2004, 21, 1712–1718. [Google Scholar] [CrossRef]
- Nutzmann, H.W.; Fischer, J.; Scherlach, K.; Hertweck, C.; Brakhage, A.A. Distinct amino acids of histone H3 control secondary metabolism in Aspergillus nidulans. Appl. Environ. Microb. 2013, 79, 6102–6109. [Google Scholar] [CrossRef]
- Fischer, J.; Muller, S.Y.; Netzker, T.; Jager, N.; Gacek-Matthews, A.; Scherlach, K.; Stroe, M.C.; Garcia-Altares, M.; Pezzini, F.; Schoeler, H.; et al. Chromatin mapping identifies BasR, a key regulator of bacteria-triggered production of fungal secondary metabolites. Elife 2018, 7, 40969. [Google Scholar] [CrossRef]
- Gottfried, S.; Koloamatangi, S.; Daube, C.; Schiemann, A.H.; Sattlegger, E. A genetic approach to identify amino acids in Gcn1 required for Gcn2 activation. PLoS ONE 2022, 17, e277648. [Google Scholar] [CrossRef] [PubMed]
- Vazquez, D.A.C.; Dever, T.E.; Hinnebusch, A.G. Mutations in the alpha subunit of eukaryotic translation initiation factor 2 (eIF-2 alpha) that overcome the inhibitory effect of eIF-2 alpha phosphorylation on translation initiation. Proc. Natl. Acad. Sci. USA 1993, 90, 7215–7219. [Google Scholar] [CrossRef]
- Maeda, T.; Takekawa, M.; Saito, H. Activation of yeast PBS2 MAPKK by MAPKKKs or by binding of an SH3-containing osmosensor. Science 1995, 269, 554–558. [Google Scholar] [CrossRef] [PubMed]
- Saito, H.; Posas, F. Response to hyperosmotic stress. Genetics 2012, 192, 289–318. [Google Scholar] [CrossRef]
- Liu, Y.; Li, Y.; Ma, L.; Deng, H.; Huang, Y.; Jiang, Q.; Yang, Y.; Bi, Y.; Prusky, D.B. The transmembrane protein AaSho1 is essential for appressorium formation and secondary metabolism but dispensable for vegetative growth in pear fungal Alternaria alternata. Fungal Biol. 2022, 126, 139–148. [Google Scholar] [CrossRef]
- Zarrinpar, A.; Bhattacharyya, R.P.; Nittler, M.P.; Lim, W.A. Sho1 and Pbs2 act as coscaffolds linking components in the yeast high osmolarity MAP kinase pathway. Mol. Cell 2004, 14, 825–832. [Google Scholar] [CrossRef] [PubMed]
- Boisnard, S.; Ruprich-Robert, G.; Florent, M.; Da, S.B.; Chapeland-Leclerc, F.; Papon, N. Role of Sho1p adaptor in the pseudohyphal development, drugs sensitivity, osmotolerance and oxidant stress adaptation in the opportunistic yeast Candida lusitaniae. Yeast 2008, 25, 849–859. [Google Scholar] [CrossRef] [PubMed]
- Watanabe, S.; Yamashita, K.; Ochiai, N.; Fukumori, F.; Ichiishi, A.; Kimura, M.; Fujimura, M. OS-2 mitogen activated protein kinase regulates the clock-controlled gene ccg-1 in Neurospora crassa. Biosci. Biotech. Bioch. 2007, 71, 2856–2859. [Google Scholar] [CrossRef][Green Version]
- Igbalajobi, O.; Yu, Z.; Fischer, R. Red- and Blue-Light Sensing in the Plant Pathogen Alternaria alternata Depends on Phytochrome and the White-Collar Protein LreA. Mbio 2019, 10, 00371-19. [Google Scholar] [CrossRef] [PubMed]

| Reaction | Name | Primer Sequence(5′ to 3′) |
|---|---|---|
| Promoter cloning | swnK-PF1 | CGGGGTACCTCGATAGCAGGTAGCAAGCG |
| swnK-PF2 | CGGGGTACCTGCCCCTTATCTCATTTCTACTGG | |
| swnK-PF3 | CGGGGTACCCCACGCCTCTTGAGCTATCC | |
| swnK-PF4 | CGGGGTACCTGGCACATGCCTGTCCTATG | |
| swnK-PF5 | CGGGGTACCCGAAAGTTGCAGGGCGATTC | |
| swnK-R | GGAAGATCTGTCGTGGTCTGAGATGGCTT | |
| Primary library identification | pDONR222-F | GTAAAACGACGGCCAG |
| pDONR222-R | CAGGAAACAGCTATGAC | |
| Secondary library identification | T7 | TAATACGACTCACTATAGGGC |
| 3′AD | AGATGGTGCACGATGCACAG | |
| For amplification of hp bait sequence | hp-F | CGGGGTACCCCCCGGTTCCACCAAGTTTT |
| hp-R | CCGCTCGAGTCGTGCTCATAGGACAGGCA | |
| Identification of bait vector and strain | YP-hp-F | GAGAGCAACCATCAAGCACC |
| YP-hp-R | TGTTAGGATGGGCAAGGCAT | |
| Identification of p53-AbAi positive control vector and strain | p53-F | GTTCCTTATATGTAGCTTTCGACAT |
| p53-R | GCGTGTCTATAGAAGTATAG |
| Number | NCBI Number | Annotation Information | Species | Number of Clones |
|---|---|---|---|---|
| h1 | OWY48836.1 | C2H2 transcription factor protein | Alternaria alternata | 14 |
| h2 | XP_043173239.1 | uncharacterized protein | Alternaria atra | 2 |
| h3 | KAH6861725.1 | mitochondrial F1-F0 ATP synthase subunit F of fungi-domain-containing protein | Alternaria alternata | 2 |
| h4 | KAH6859764.1 | RING-14 protein | Alternaria alternata | 1 |
| h5 | ANG83691.1 | histone H3, partial | Alternaria tenuissima | 3 |
| h6 | XP_028500422.1 | ATP-dependent RNA helicase | Alternaria arborescens | 1 |
| h7 | OWY47682.1 | tuberous sclerosis 1 protein | Alternaria alternata | 1 |
| h8 | XP_038789159.1 | eukaryotic translation initiation factor 2 subunit alpha | Alternaria burnsii | 1 |
| h9 | XP_046022265.1 | high osmolarity signaling protein sho1 | Alternaria rosae | 1 |
| h10 | XP_018380507.1 | bli-3 protein | Alternaria alternata | 1 |
| h11 | OWY43746.1 | ATP synthase F1 gamma | Alternaria alternata | 1 |
| h12 | 3 |
Disclaimer/Publisher’s Note: The statements, opinions and data contained in all publications are solely those of the individual author(s) and contributor(s) and not of MDPI and/or the editor(s). MDPI and/or the editor(s) disclaim responsibility for any injury to people or property resulting from any ideas, methods, instructions or products referred to in the content. |
© 2023 by the authors. Licensee MDPI, Basel, Switzerland. This article is an open access article distributed under the terms and conditions of the Creative Commons Attribution (CC BY) license (https://creativecommons.org/licenses/by/4.0/).
Share and Cite
Xue, J.; Zhang, H.; Zhao, Q.; Cui, S.; Yu, K.; Sun, R.; Yu, Y. Construction of Yeast One-Hybrid Library of Alternaria oxytropis and Screening of Transcription Factors Regulating swnK Gene Expression. J. Fungi 2023, 9, 822. https://doi.org/10.3390/jof9080822
Xue J, Zhang H, Zhao Q, Cui S, Yu K, Sun R, Yu Y. Construction of Yeast One-Hybrid Library of Alternaria oxytropis and Screening of Transcription Factors Regulating swnK Gene Expression. Journal of Fungi. 2023; 9(8):822. https://doi.org/10.3390/jof9080822
Chicago/Turabian StyleXue, Jiaqi, Haodong Zhang, Qingmei Zhao, Shengwei Cui, Kun Yu, Ruohan Sun, and Yongtao Yu. 2023. "Construction of Yeast One-Hybrid Library of Alternaria oxytropis and Screening of Transcription Factors Regulating swnK Gene Expression" Journal of Fungi 9, no. 8: 822. https://doi.org/10.3390/jof9080822
APA StyleXue, J., Zhang, H., Zhao, Q., Cui, S., Yu, K., Sun, R., & Yu, Y. (2023). Construction of Yeast One-Hybrid Library of Alternaria oxytropis and Screening of Transcription Factors Regulating swnK Gene Expression. Journal of Fungi, 9(8), 822. https://doi.org/10.3390/jof9080822

